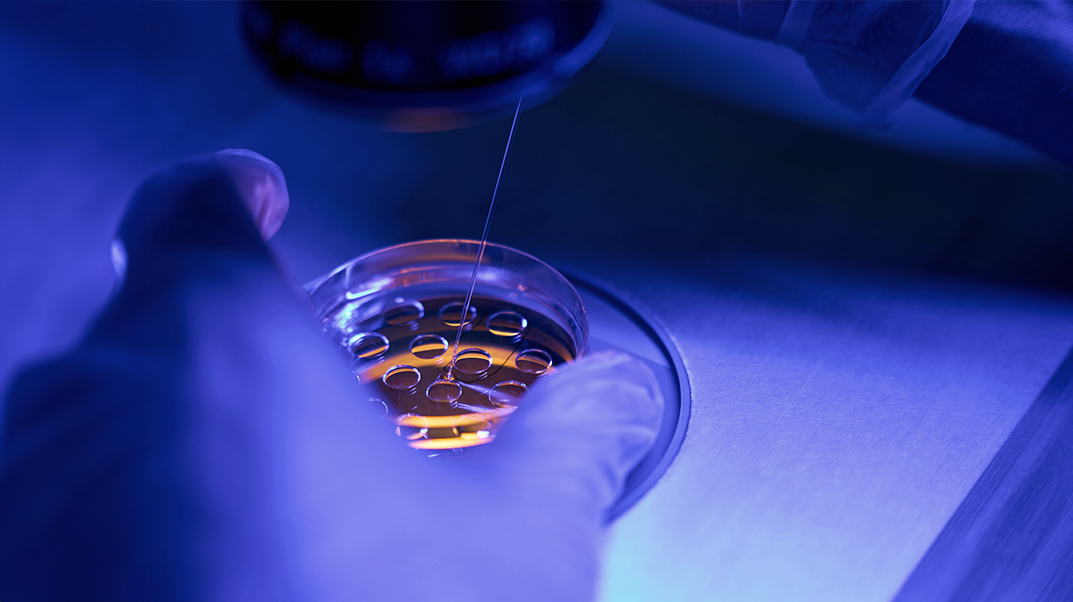

"PGT با تلفیق IVF و آنالیز مولکولی، جنینها را از نظر تعداد و ساختار کروموزومها و جهشهای مونوژنیک ارزیابی میکند و امکان جلوگیری از انتقال بسیاری از بیماریهای ارثی و کاهش سقطهای ناشی از ناهنجاری کروموزومی را فراهم میسازد."
تست ژنتیکی پیش از لانهگزینی (PGT) آزمایشی است که به متخصصان ناباروری اجازه میدهد مواد ژنتیکی جنین را پیش از فرآیند انتقال IVF بررسی کنند. این روش قادر است جنینهای سالم را از جنینهایی که ناهنجاریهای کروموزومی یا ژنتیکی دارند، تفکیک نماید.
تست ژنتیکی پیش از لانهگزینی (PGT) چیست؟
تست ژنتیکی پیش از لانهگزینی یا (PGT) نوعی آزمایش ژنتیکی است که ارائهدهندگان خدمات درمانی میتوانند بر روی جنینهای ایجادشده از طریق لقاح آزمایشگاهی (IVF) انجام دهند. این روش به متخصص ناباروری شما اجازه میدهد جنینها را برای شرایط ژنتیکی یا کروموزومی خاص غربالگری کند، پیش از انتقال جنین به رحم.
نتایج آزمایش PGT به زوجها امکان انتخاب جنینهایی را میدهد که فاقد اختلالات ژنتیکی یا کروموزومی هستند، که این امر شانس بارداری سالم را افزایش میدهد.
کاربردهای PGT
PGT ابزاری است که متخصصان ناباروری برای کمک به زوجهای تحت IVF استفاده میکنند تا بهترین شانس بارداری سالم و فرزند سالم را داشته باشند. این روش از انتقال بیماری ژنتیکی جلوگیری کرده یا از ادامه فرآیند IVF در مواردی که احتمال موفقیت پایین است، ممانعت میکند. همچنین به زوجها کمک میکند جنین با جنسیت مورد نظر خود را انتخاب کنند.
تفاوت با غربالگری حامل ژن
PGT با آزمایش ژنتیکی پیش از تولد (مانند غربالگری حامل ژن) متفاوت است. غربالگری حامل ژن تغییرات کوچک در ژنهای والدین بیولوژیک را تشخیص میدهد. اگر هر دو شما و شریکتان حامل یک بیماری باشید، جنین ایجادشده ریسک بالاتری برای ابتلا به آن بیماری تکژنی دارد؛ افراد حامل چنین بیماریهایی ممکن است PGT را برای بررسی جنینهایشان انتخاب کنند.
نامهای دیگر PGT
PGT یا تشخیص ژنتیکی پیش از لانهگزینی (PGD)
PGS یا غربالگری ژنتیکی پیش از لانهگزینی (PGS)
توصیهها
زوجهایی که PGT را در نظر دارند باید با تیم درمانیشان در مورد خطرات و فواید آزمایش جنینها صحبت کنند. مشاور ژنتیک نیز میتواند وضعیت شما را توضیح داده و نوع مناسب آزمایش را توصیه کند.
دلایل انجام PGT چیست؟
افرادی که تحت IVF هستند ممکن است تست ژنتیکی پیش از لانهگزینی (PGT) را برای بررسی جنینها از نظر شرایط ژنتیکی و/یا کروموزومی انتخاب کنند. این اطلاعات از انتقال جنین با وضعیت پزشکی جدی یا جنینی که احتمال ایمپلنتاسیون کمتر و ریسک سقط بالاتری دارد، جلوگیری میکند.
شما ممکن است این تست را انتخاب کنید اگر:
انواع PGT
متخصصان ناباروری سه نوع تست ژنتیکی پیش از لانهگزینی انجام میدهند:
PGT-A
«A» به معنای آنوپلوئیدی است؛ حالتی که سلول کروموزومهای اضافی یا ناقص دارد که یکی از علل اصلی شکست ایمپلنتاسیون و سقط میباشد. این تست بررسی میکند آیا جنین ۴۶ کروموزوم (۲۳ از هر والد) دارد. جنین با تعداد بیشتر یا کمتر از ۴۶ کروموزوم، احتمال بارداری سالم کمتری دارد. مثالهای اختلالات کروموزومی شامل سندرم داون، سندرم ترنر و سندرم پاتاو میباشد.
PGT-M
این تست جنین را برای شرایط خاصی که یکی از والدین (یا هر دو) حامل آن است، بررسی میکند. وقتی هر دو والد حامل شرایط ژنتیکی هستند، شانس انتقال به فرزند بالاتر است. مثالهای بیماریهای تکژنی: آنمی داسیشکل، فیبروز کیستیک، دیستروفی عضلانی و آتروفی عضلانی نخاعی. این تست همچنین جنینهای سازگار با آنتیژن لکوسیت انسانی (HLA) را شناسایی میکند.
PGT-SR
بازآراییهای کروموزومی به کروموزومهایی اشاره دارد که از نظر ساختاری متفاوت به نظر میرسند. انواع اصلی بازآراییها شامل وارونگی و جابهجایی است. هر دو نوع به این معناست که مواد ژنتیکی جنین حاوی خطاهایی است که میتواند منجر به مشکلات جدی سلامتی و سقطهای مکرر شود.
جزئیات تست
PGT چگونه کار میکند؟
تست پیش از لانهگزینی تنها برای زوجهایی که تحت درمان IVF هستند، در دسترس است. در یک چرخه IVF معمولی، متخصص ناباروری جنینها را بر اساس ظاهر آنها زیر میکروسکوپ برای انتقال به رحم انتخاب میکند. این کار سرنخهایی درباره سلامت جنین ارائه میدهد.
تست پیش از لانهگزینی این فرآیند را یک گام جلوتر میبرد و اطلاعات بسیار بیشتری درباره ترکیب ژنتیکی و کروموزومی جنین فراهم میکند. این اطلاعات به متخصصان ناباروری و زوجها اجازه میدهد جنینهایی را انتخاب کنند که بیشترین شانس ایمپلنتاسیون موفق را دارند.
مراحل خاص تست ژنتیکی پیش از لانهگزینی
مراحل خاص تست ژنتیکی پیش از لانهگزینی شامل موارد زیر است:
آیا خطری دارد؟
خیر، PGT هیچ خطر اضافی فراتر از خطرات معمول IVF ندارد. آزمایش چند سلول از لایههای خارجی جنین در حال رشد هیچ تأثیر منفی بر جنین نشان نداده است.
PGT زمان و هزینه بیشتری به فرآیند IVF اضافه میکند. با متخصص ناباروری یا مشاور ژنتیک خود در مورد توصیه به انجام تست ژنتیکی پیش از لانهگزینی مشورت کنید.
نتایج و پیگیری
چه نوع نتایجی از PGT دریافت میکنید؟
نتایج بستگی به نوع تست PGT دارد، اما بیشتر به صورت نرمال یا غیرنرمال گزارش میشود.
1. نتایج :PGT-A نرمال اگر جنین ۴۶ کروموزوم داشته باشد. غیرنرمال اگر کروموزومها زیاد یا کم باشند. ممکن است موزائیک باشد؛ یعنی حاوی سلولهای هم نرمال و هم غیرنرمال.
2. نتایج :PGT-M نرمال یا غیرنرمال برای هر بیماری که بررسی شده. نرمال یعنی جنین آن بیماری خاص را ندارد؛ غیرنرمال یعنی حامل یا مبتلا است.
3. نتایج :PGT-SR نرمال اگر هیچ بازآرایی کروموزومی یافت نشود؛ غیرنرمال اگر یکی یا بیشتر شناسایی شود.
آیا نتایج دقیق هستند؟
تست پیش از لانهگزینی نمیتواند تضمین کند جنین بدون هیچ مشکل سلامتی متولد شود. مانند بیشتر تستها، احتمال کمی برای عدم دقت وجود دارد. به همین دلیل، متخصصان ژنتیک آمنیوسنتز یا نمونهبرداری پرزهای کوریونی (CVS) در دوران بارداری را برای تأیید نتایج PGT توصیه میکنند.
سوالات رایج اضافی
چرا PGT بحثبرانگیز است؟
برخی افراد معتقدند مداخلات پزشکی خاص غیراخلاقی است. موضوعات سلامت مانند اتانازی اغلب اختلافنظر ایجاد میکنند، زیرا هر کس نظر خودش را درباره درستی یا نادرستی اخلاقی دارد.
بسیاری باور دارند «انتخاب» جنینها غیراخلاقی است به دلیل عملی به نام یوژنیک. یوژنیک انتخاب یا ترجیح صفات ژنتیکی یا ارثی مطلوب برای بهبود گونه انسانی است. در تاریخ، یوژنیک تبعیضآمیز بود و به اعمال وحشتناک منجر شد. منتقدان PGT میگویند این یک شیب لغزنده است و میتواند به راهی برای رد یا حذف جمعیتهایی از افراد با ناتوانیها یا بیماریهای ژنتیکی منجر شود. اما حامیان باور دارند این راهی برای پیشگیری از رنج و درد غیرضروری است.
آیا PGT در ایالات متحده قانونی است؟
بله، انجام تست ژنتیکی پیش از لانهگزینی در آمریکا قانونی است. هیچ مقررات دولتی بر این عمل وجود ندارد. این یعنی هر کسی میتواند PGT را به هر دلیلی انجام دهد و کاملاً به صلاح دید کلینیک ناباروری بستگی دارد. سازمان غذا و داروی آمریکا (FDA) در حال کار بر روی راههایی برای تنظیم PGT است. بسیاری از کارشناسان انتظار دارند در نهایت قوانینی وضع شود.
نتیجهگیری
IVF میتواند برای زوجها بسیار چالشبرانگیز باشد. از نظر احساسی، جسمی و مالی طاقتفرسا است و تضمینی برای بارداری وجود ندارد. اختلالات ژنتیکی یا کروموزومی جنین از دلایل شایع شکست IVF است. اما تست ژنتیکی پیش از لانهگزینی میتواند شانس بارداری موفق IVF را افزایش دهد، زیرا این اختلالات را پیش از انتقال جنین شناسایی میکند.
این روش به شما و متخصص ناباروریتان اجازه میدهد جنینهای سالم را با بهترین شانس رشد انتخاب کنید. این برای برخی زوجها بسیار مفید است. اگر PGT را در نظر دارید، با مشاور ژنتیکتان در مورد توصیههایشان صحبت کنید. آنها مزایای تست را بررسی کرده و کمک میکنند تصمیم بگیرید آیا برای شما و خانوادهتان مناسب است یا نه.
ساخته شده در آزمایشگاه جهش لب
نظر خود را قرار دهید